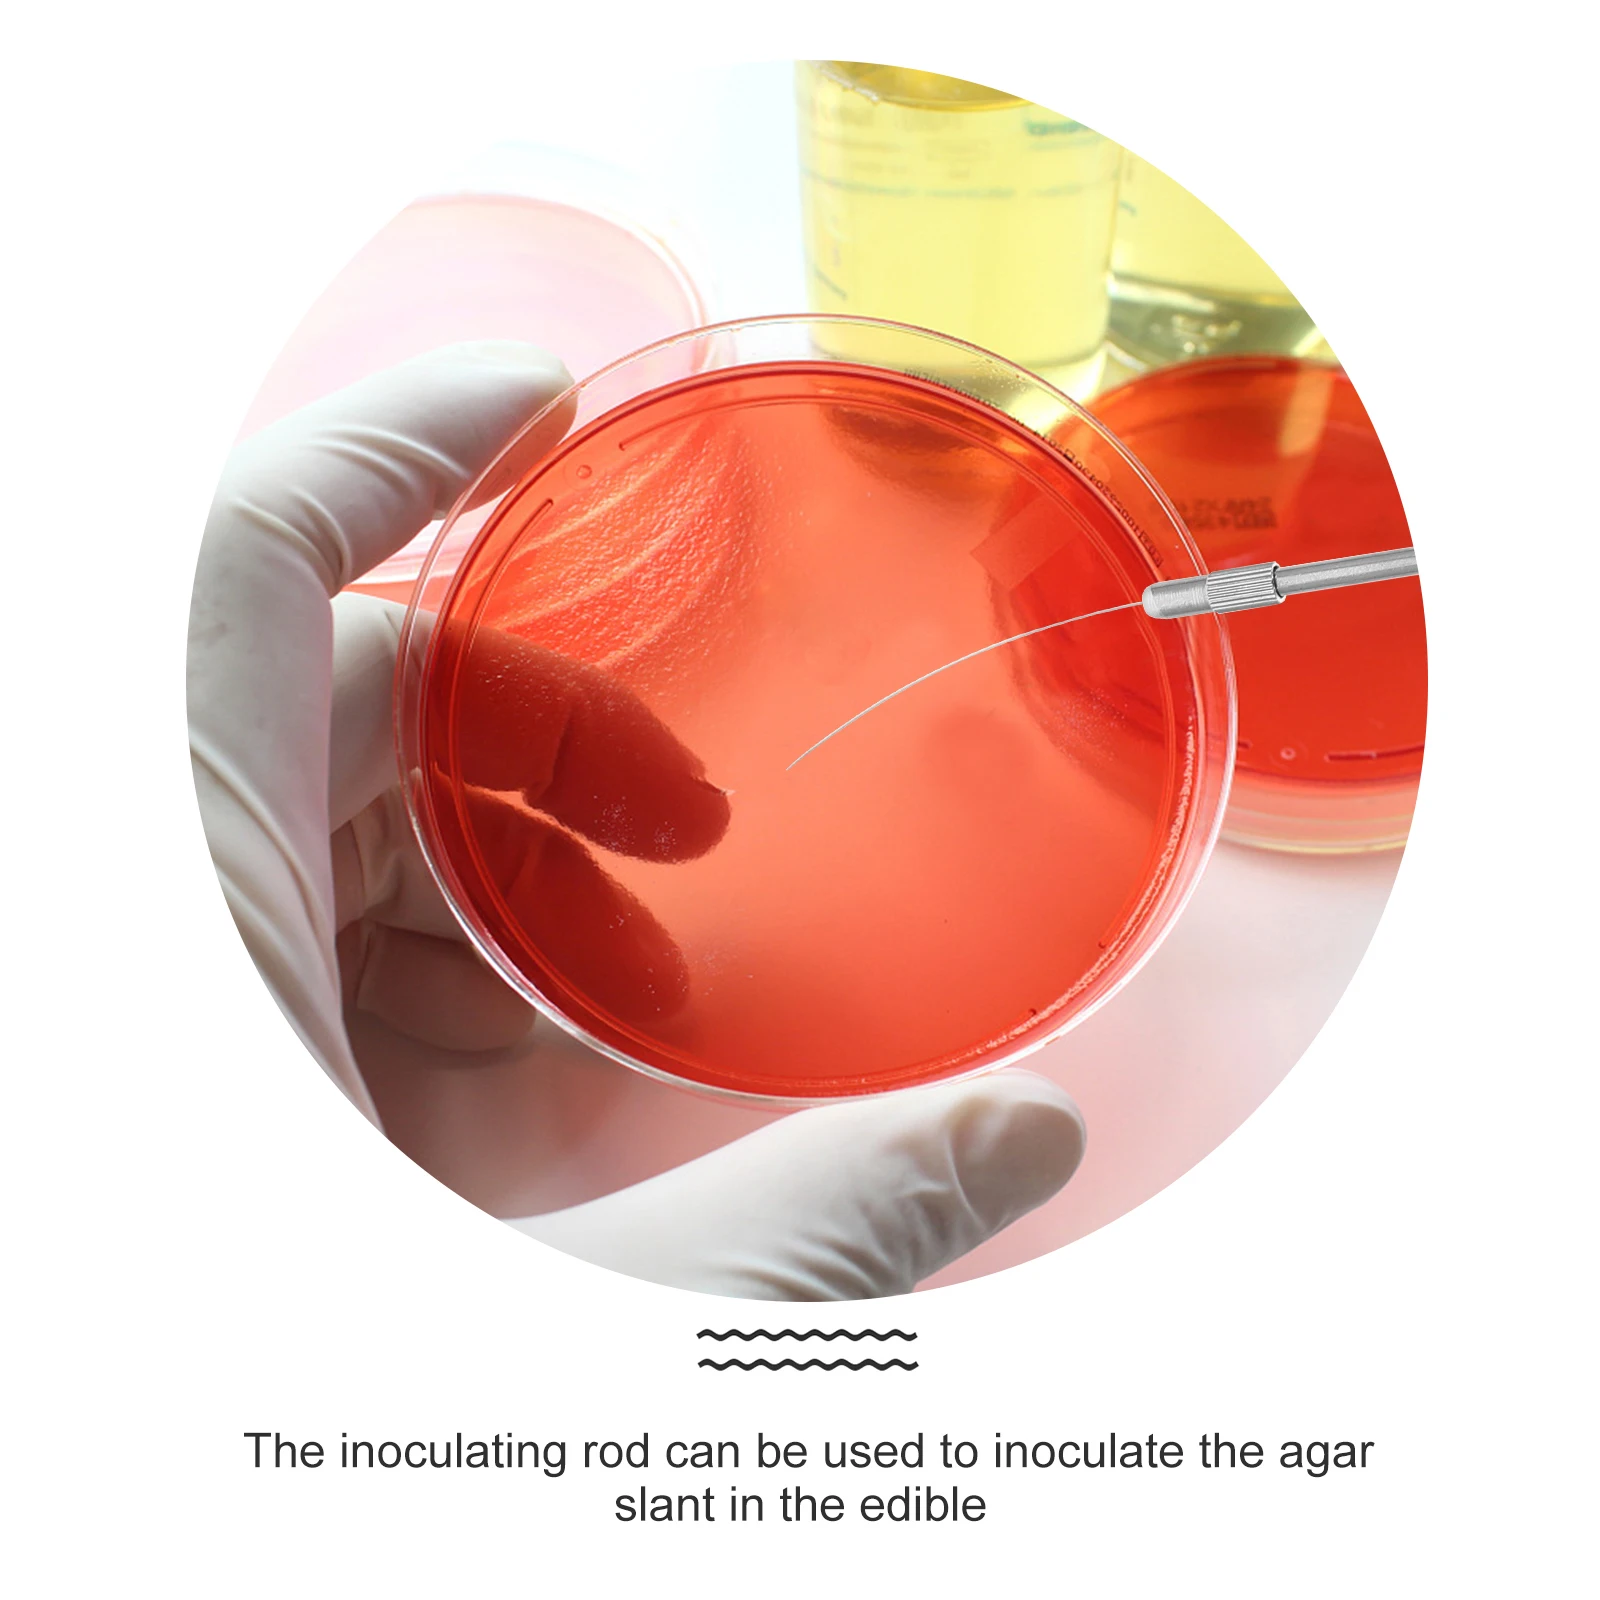
1 set Stainless Steel Inoculation Rods Lab Tools for Microbiology Experiment Random Colors Wire Loop for Culture

- Trang Chủ
- Bán chạy nhất
-
Tất cả danh mục
- Tất cả danh mục
- của phụ nữ Quần Áo
- Quần Áo của nam giới
- điện thoại & điện thoại Viễn Thông
- Computer & Office
- Điện Tử tiêu dùng
- trang sức & Phụ Kiện
- Home & Garden
- hành lý & Túi Xách
- giày
- newlv1categorytest
- Test category 06
- đồ nội thất
- Lights & Chiếu Sáng
- thể thao & Giải Trí
- trang phục Phụ Kiện
- Phụ kiện điện thoại và viễn thông
- Beauty & Health
- Novelty & Đặc Dụng
- văn phòng & Trường Học Nguồn Cung Cấp
- Giày thể thao, quần áo & phụ kiện
- Đồ lót, Vớ, Ngủ & Phòng Chờ Mặc
- đám cưới & Sự Kiện
- Linh Kiện điện tử & Nguồn Cung Cấp
- ô tô Xe Máy &
- An ninh và bảo vệ
- Phần Mở Rộng tóc & Wigs
- Công nghiệp & Kinh doanh
- công cụ
- mẹ và trẻ em
- Xe máy thiết bị & phụ tùng
- đồ chơi & Sở Thích
- đồng hồ
- Cải Thiện nhà
- Đồ Gia Dụng
- Sách & Hàng hóa Văn hóa
- thực phẩm
- Tất cả các cửa hàng